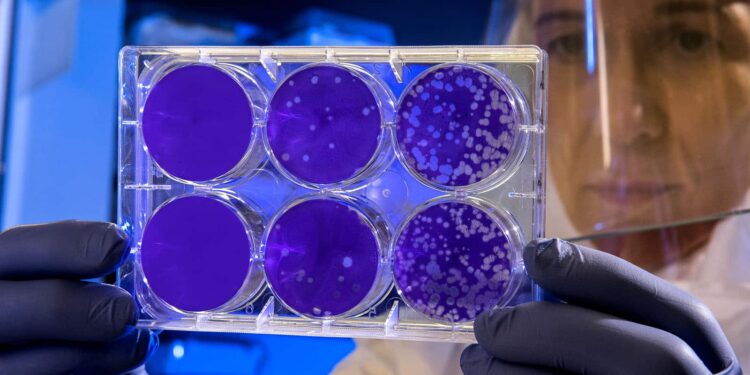
In addition to long COVID, there’s also long flu

Folks hospitalized with seasonal influenza can undergo long-term, destructive well being results, particularly involving their lungs and airways.
The brand new examine evaluating the viruses that trigger COVID-19 and the flu additionally reveals that within the 18 months after an infection, sufferers hospitalized for both COVID-19 or seasonal influenza confronted an elevated danger of loss of life, hospital readmission, and well being issues in lots of organ methods. Additional, the time of highest danger was 30 days or later after preliminary an infection.
Because the COVID-19 pandemic started, intensive analysis has emerged detailing the virus’s capability to assault a number of organ methods, probably leading to a set of tolerating and sometimes disabling well being issues often called long COVID.
“The concept that COVID-19 or flu are simply acute sicknesses overlooks their bigger long-term results on human well being.”
“The examine illustrates the excessive toll of loss of life and lack of well being following hospitalization with both COVID-19 or seasonal influenza,” says senior writer Ziyad Al-Aly, a scientific epidemiologist at Washington College in St. Louis. “It’s essential to notice that the well being dangers have been larger after the primary 30 days of an infection. Many individuals assume they’re over COVID-19 or the flu after being discharged from the hospital. Which may be true for some folks. However our analysis exhibits that each viruses could cause long-haul sickness.”
The findings seem in The Lancet Infectious Diseases.
The statistical evaluation spanned as much as 18 months post-infection and included a comparative analysis of risks of death, hospital admissions, and 94 opposed well being outcomes involving the physique’s main organ methods.
“A evaluation of previous research on COVID-19 versus the flu targeted on a short-term and slim set of well being outcomes,” says Al-Aly, who treats sufferers inside the VA St. Louis Well being Care System and is an assistant professor of medication at Washington College. “Our novel strategy in contrast the long-term well being results of an enormous array of circumstances. 5 years in the past, it wouldn’t have occurred to me to look at the potential of a ‘lengthy flu.’ A serious lesson we discovered from SARS-CoV-2 is that an an infection that originally was thought to solely trigger transient sickness can also result in power illness. This revelation motivated us to have a look at long-term outcomes of COVID-19 versus flu.
“We needed to know whether or not and to what diploma folks with flu additionally expertise long-term well being results,” Al-Aly says. “The large reply is that each COVID-19 and the flu led to long-term well being issues, and the massive aha second was the belief that the magnitude of long-term well being loss eclipsed the issues that these sufferers endured within the early section of the an infection. Lengthy COVID is rather more of a well being downside than COVID, and lengthy flu is rather more of a well being downside than the flu.”
Nevertheless, the general danger and prevalence of loss of life, hospital admissions, and lack of well being in lots of organ methods are considerably larger amongst COVID-19 sufferers than amongst those that have had seasonal influenza, Al-Aly says. “The one notable exception is that the flu poses larger dangers to the pulmonary system than COVID-19,” he says. “This tells us the flu is really extra of a respiratory virus, like we’ve all thought for the previous 100 years. By comparability, COVID-19 is extra aggressive and indiscriminate in that it will possibly assault the pulmonary system, however it will possibly additionally strike any organ system and is extra more likely to trigger deadly or extreme circumstances involving the center, mind, kidneys, and different organs.”
The researchers analyzed de-identified medical data in a database maintained by the USA Division of Veterans Affairs, the nation’s largest built-in health-care supply system. They evaluated data involving 81,280 sufferers hospitalized for COVID-19 sooner or later from March 1, 2020, by means of June 30, 2022, in addition to 10,985 sufferers hospitalized for seasonal influenza sooner or later from October 1, 2015, by means of February 28, 2019.
Sufferers represented a number of ages, races, and sexes.
Concerning each viruses, affected person vaccination standing didn’t have an effect on outcomes. These within the COVID-19 cohort have been hospitalized throughout the pre-delta, delta, and omicron eras.
Throughout the general 18-month examine interval, sufferers who had COVID-19 confronted a 50% larger danger of loss of life than these with seasonal influenza. This corresponded to about eight extra deaths per 100 individuals within the COVID-19 group than amongst these with the flu.
Though COVID-19 confirmed a better danger of well being loss than seasonal influenza, an infection with both virus carried important danger of incapacity and illness. The researchers discovered COVID-19 exhibited elevated danger of 68% of well being circumstances examined throughout all organ methods (64 of the 94 opposed well being outcomes studied), whereas the flu was related to elevated danger of 6% of well being circumstances (six of the 94)—largely within the respiratory system.
Additionally, over 18 months, COVID-19 sufferers skilled an elevated danger of hospital readmission in addition to admission to an intensive care unit (ICU). For each 100 individuals in every group, there have been 20 extra hospital admissions and 9 extra ICU admissions in COVID-19 than flu.
“Our findings spotlight the continued want to cut back the chance of hospitalization for these two viruses as a approach to alleviate the general burden of well being loss in populations,” Al-Aly says. “For each COVID-19 and seasonal influenza, vaccinations might help forestall extreme illness and cut back the chance of hospitalizations and loss of life. Optimizing vaccination uptake should stay a precedence for governments and well being methods in all places. That is particularly necessary for weak populations such because the aged and people who find themselves immunocompromised.”
In each COVID-19 and the flu, greater than half of loss of life and incapacity occurred within the months after an infection versus the primary 30 days, the latter of which is called the acute section.
“The concept that COVID-19 or flu are simply acute sicknesses overlooks their bigger long-term results on human well being,” Al-Aly says. “Earlier than the pandemic, we tended to belittle most viral infections by relating to them as considerably inconsequential: ‘You’ll get sick and recover from it in a couple of days.’ However we’re discovering that’s not everybody’s expertise. Some individuals are ending up with severe long-term well being points. We have to get up to this actuality and cease trivializing viral infections and perceive that they’re main drivers of power illnesses.”